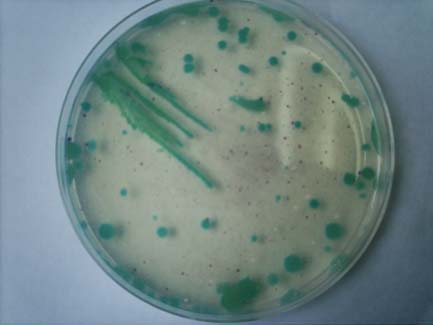

食肉業界の品質管理室に勤めている■■と申します。
寒天培地についてお聞きしたいことがあります。弊社では自社製品を使用した“コロッケ”を製造しています。現在, 細菌検査として一般生菌数 (標準寒天培地を使用), 大腸菌群・大腸菌 (ESコリマーク寒天培地を使用) を項目としていますが, 先日, 一般生菌数が10の6乗, 大腸菌群・大腸菌が添付した写真のように出ました。原因を探していくと, “パン粉”が同じような状況で検出され, 原因と考えられたのですが, パン粉製造メーカーに検査を依頼したところ,「一般生菌数は同じように10の6乗検出されたが, 大腸菌群・大腸菌は“陰性”」という報告が返ってきました。このメーカー側の検査は, デスオキシコレート寒天培地を使用しているとのこと。同じ検査でも, 培地によって大きな差があり過ぎるように思います。どうしてこのような差が出てくるのでしょうか。
また, 加工食品の検査に適する培地はどれで, どのくらいの培養時間を要するのでしょうか。
お忙しい中申し訳ありませんが, 初心者のため, 細かく説明していただけると大変嬉しいです。よろしくお願いいたします。
(クリックで拡大)
1. 培地の判定について, 添付された写真から“緑色集落”を確認しました。この集落は, ESコリマーク寒天における大腸菌・大腸菌群の定型的集落ではありません。ついては「大腸菌・大腸菌群 陰性」と判定します。ESコリマーク寒天培地に発育した青〜青紫色の集落は“大腸菌”とします。またピンク〜赤紫色の集落は“大腸菌以外の大腸菌群”とします。ESコリマーク寒天の発色機序については, 弊社ホームーページをご参照ください[http://www.eikenkizai.co.jp/product/baichi/escolimark/escolimark.html]。
2. 加工食品の大腸菌群の検査については, 製品の特性, 加工条件などを勘案して基準および試験法を決定します。検査法は, 「食品衛生法」の試験法を参考にして決定している場合が多いようです。例えば, 氷菓, 無加熱摂取冷凍食品, 加熱後摂取冷凍食品 (凍結直前加熱) の試験方法は, 試料をデスオキシコーレイト寒天 (デソ培地) に接種し, 35℃で20±2時間培養した後, 暗赤色集落の有無を観察します (推定試験陽性)。暗赤色集落はEMB寒天に画線し, 35℃で24±2時間培養した後, 金属光沢または暗紫赤色集落の有無を観察します (確認試験)。EMB培地上の異なる集落2個以上を乳糖ブイヨンと寒天斜面に接種します。乳糖からのガス産生, 寒天斜面の菌がグラム陰性の無芽胞桿菌であれば完全試験「陽性」となり“大腸菌群陽性”とします。これは, 大腸菌群の定義「グラム陰性の無芽胞桿菌, 乳糖を分解してガスと酸を産生する通性嫌気性の一群の細菌群」を網羅するための試験で, 5日間かかり, 自主衛生管理のための試験としては手間や時間がかかり過ぎます。このため自主衛生管理では, 培地上の定型的集落の有無や数を試験 (推定試験) している場合が多いようです。ただしこの場合には, 完全試験まで行っていないので「推定大腸菌群」あるいは「デソ赤変菌」, または検査法を表記するなどして報告します。